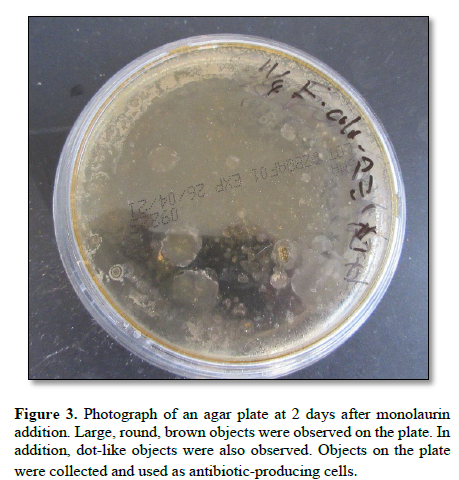
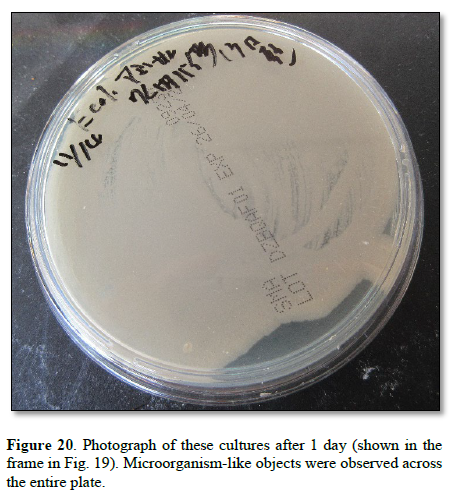
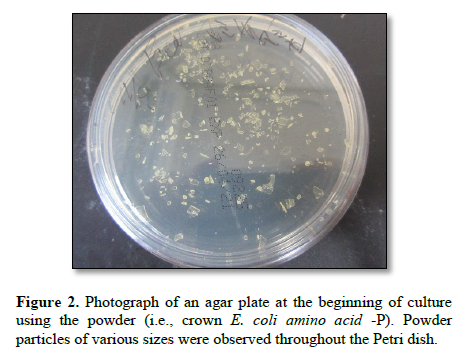
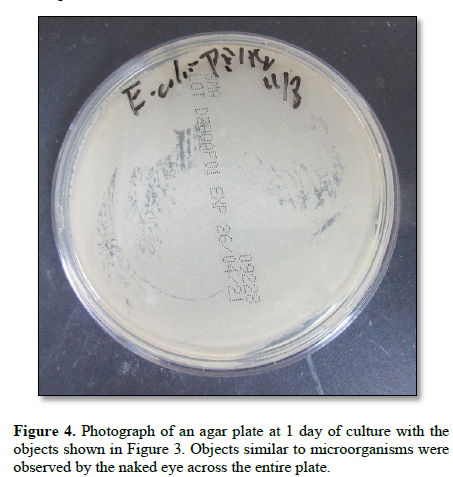
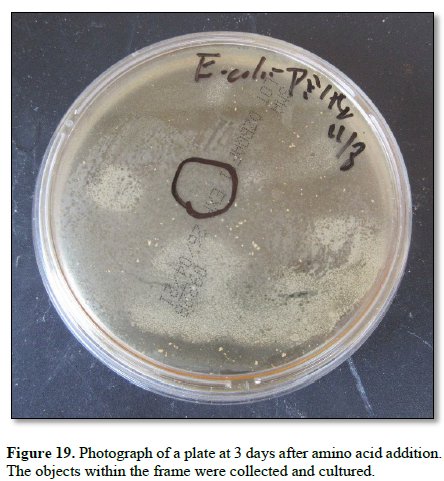

84
Views & Citations10
Likes & Shares
The present study examined whether this cell proliferation and objects (crown E. coli-amino acid cells nema) were observed in cultures of egg white powder enclosing DNA (E. coli) crown cells produced using amino acids as a partner.
The findings showed that crown E. coli-amino acid cells nema could be produced using this combination.
Keywords: DNA (E. coli) crown cells, sphingosine-DNA, antibiotic crown E. coli-amino acids cells, Amino acids, Crown cells nema
Moreover, it was demonstrated that these antibiotic-producing cells, when cultured on agar plates and a partner was added, cell proliferation and objects that varied in shape and size were observed; these cells are referred to as crown cells nema.
The present experiments examined whether antibiotic-producing cells produced from DNA (E . coli) crown cells and amino acids could be used to produce crown E. coli amino acid cells nema.
MATERIALS AND METHODS
Antibiotic crown E. coli-amino acids cells were prepared using the following three steps:
Step 1: Preparation of DNA crown cells
Step 2: Preparation of powder.
Step 3: Cultivation of powder (Antibiotic crown cells)
MATERIALS
Sph (Tokyo Kasei, Tokyo, Japan), DNA (E. coli, Sigma-Aldrich, USA), adenosine (Wako, Tokyo, Japan), monolaurin (Tokyo Kasei), and adenosine-monolaurin (A-M) compound (12). Monolaurin solutions were prepared to a final concentration of 0.1 M in distilled water. Agar plates were prepared using standard agar medium (SMA; AS ONE, Japan). Amino acids (MEM Essential Amino Acid Solution (´50), Fujifilm, Wako) were used as a partner.
Step 1
Preparation of DNA (E. coli) crown cells (11,12).
Briefly, 180 mL of Sph (10 mM) and 90 mL of DNA (1.7µg/mL) were combined, and the mixture was heated and cooled twice. Then, A-M solution (12) was added and the mixture was incubated for 15 min at 37°C. Following the addition of monolaurin solution, the mixture was incubated for 5 min at 37°C to produce synthetic DNA crown cells.
These cells were then added to egg white and incubated for 7 days at 37°C. Then, the egg white was recovered and used as DNA (E. coli) crown cells.
Step 2
Preparation of egg white powder-enclosed DNA crown cells with amino acids
- First, 3 mL of amino acids solution was mixed with 3 mL of egg white.
- The mixture was then incubated for 5 hours at 37°
- Approximately 20 mL of fresh egg white was then added to the mixture.
- The mixture was then plated onto two Petri dishes and dried for 1–2 days at 37°
- The dried material was then collected and ground to a powder using a mortar and pestle.
- The powder, named crown coli amino acid -P, was stored at room temperature and used as necessary (Figure 1).

Step 3
Cultivation of powder (preparation of antibiotic-producing cells)
Approximately 50 mg of powder (crown E. coli amino acids -P) was added to an agar plate and incubated for 2 days at 37°C. Then, approximately 1.5 mL of 0.1 M monolaurin solution was spread onto each plate, which was then incubated for 2 days at 37°C. Approximately 6.0 mL of distilled water was then added to the plate and spread on the plate surface and the objects on the plate were recovered. Suspended objects were used as antibiotic-producing cells.
Cultivation of antibiotic-producing cells
A total of 200 mL of sample was placed onto an agar plate and incubated for 1 day at 37°C.
Preparation of crown E. coli amino acid cells nema
Experiment 1
After 7 days of antibiotic-producing cell culture, approximately 1.5 mL of amino acid solution was added to an agar plate and incubated for 5 h, 1 day, 2 days and 3 days at 37°C.
Experiment 2
After 3 days of culture after amino acid addition in Experiment 1, objects that grew on the plate (Figure 19, within the frame) were collected and transplanted into a new plate. These objects were incubated for 1 day at 37°C.
These objects that grew on the plate were observed with the naked eye or under a light microscope.
RESULTS AND DISCUSSION
Figure 2 shows a photograph of an agar plate at the beginning of culture using the powder (i.e., crown E. coli amino acid -P). Powder particles of various sizes were observed throughout the Petri dish.

Figure 3 shows a photograph of an agar plate at 2 days after monolaurin addition.
Figure 4 shows a photograph of an agar plate at 1 day of culture with the objects shown in Figure 3. Objects similar to microorganisms were observed by the naked eye across the entire plate.

Figure 5 shows the microscopic appearance of the objects (e.g., 1) before the addition of amino acids after 1 day of culture on the agar plate shown in Figure 4. Many amorphous objects (Figure 5, ←) were observed. The approximate size of these objects was 100 mm (Figure 5, ←)

Figure 6 shows the microscopic appearance of objects (e.g., 2) before amino acid addition to the agar plate shown in Figure 4. Objects with protrusions on the surface were observed (Figure 6a).

Also, amorphous objects like Konpeito were observed (Figure 6b). The approximate size of these objects was 100 mm (Figure 6b).
Figure 7 shows the microscopic appearance of objects immediately after adding amino acids to the plate shown in Figure 4. Amorphous objects were observed (Figure 7←).
The approximate size of the objects shown in Figure 7(←) was 300 mm.

Figure 8 shows the microscopic appearance of objects at 5 h after amino acid addition. Fluffy round objects (→) were observed. The size of the object shown in Figure 8 (←) was approximately 150 mm in diameter.

Figure 9 shows the microscopic appearance of objects (e.g., 1) at 1 day after amino acid addition. Numerous round objects were observed (Figure 9a). In addition, objects consisting of a twisted membrane were observed (Figure 9b).
The size of the object shown in Figure 9c was approximately 60 mm.

Figure 10 shows the microscopic appearance (e.g., 2) of objects after 1 day of amino acid addition. Numerous rod-like objects were observed (Figure 10a).
The approximate size of the rod-like objects shown in Figure 10b was 100 mm.

Figure 11 shows the microscopic appearance (e.g., 3) of objects at 1 day after amino acid addition. Assemblies of rod-shaped objects were observed (Figure 11a). In addition, an object with jagged membrane was observed. (Figure 11b). The approximate size of the objects shown in Figure 11c was 100 mm.

Figure 12 shows the microscopic appearance (e.g., 1) of objects at 2 days after amino acid addition. Assemblies of rod-like objects of various sizes were observed (Figure 12a). The size of the objects shown in Figure 12b was approximately30 mm.

Figure 13 shows the microscopic appearance (e.g., 2) of objects at 2 days after amino acid addition. Numerous round objects (Figure 13a) were observed. Also, line like objects which was constructed of rode like objects was observed (Figure 13c). The approximate size of Figure 13b was 70 mm.

Figure 14 shows the microscopic appearance (e.g., 1) of objects at 3 days after amino acid addition. Objects with membranes comprising rod-like objects (Figures 14 b and c) were observed (Figure 14a). The approximate size of Figure 14d was 60 mm.

Figure 15 shows the microscopic appearance (e.g., 2) of objects at 3 days after amino acid addition. Assemblies of round-shaped object (Figure 15 b) were observed (Figure 15a). The approximate size of Figure 15b was 150 mm.

Figure 16 shows a microscopic appearance of objects (e.g., 3) at 3 days after amino acid addition. An object containing round objects was observed (Figure 16 a). The approximate size of Figure 16b was 120 mm.

Figure 17 shows the microscopic appearance of objects (e.g., 4) at 3 days after amino acid addition. Round objects of various sizes were observed (Figure 17b). Also, round objects linked together in a chain were observed (Figure 17a). The approximate size of Figure 17b was 150 mm.

Figure 18 shows the microscopic appearance of objects (e.g., 5) at 3 days after amino acid addition. An assembly of round objects was observed (Figure 18a). The approximate size of Figure 18b was 130 mm.

Figure 19 shows a photograph of a plate at 3 days after amino acid addition. The objects within the frame were collected and cultured.
Figure 20 shows a photograph of these cultures after 1 day (shown in the frame in Figure 19). Microorganism-like objects were observed across the entire plate.

In previous studies, antibiotic-producing cells (antibiotic crown cells) were produced in combination with various DNA crown cells and partners (e.g., microorganisms such as yeast, Bacillus subtilis, cells such as salmon roe, extracts such as those from bovine meat, and chemical compounds such as peptides) (4–10).
Moreover, in previous experiments (13,14), it was demonstrated that various unique objects appeared when antibiotic crown cells produced with DNA crown cells with Glu-Glu as a partner were cultivated on agar plates and a partner was added to agar plates.
These objects were named crown Asci glu-glu cells nema and crown E.coli glu-glu cells nema, respectively (crown Asci; Asci: Ascidian and E.coli used to prepare DNA crown cells; glu-glu (Peptides): used as a partner for the crown antibiotic cells; cells nema. as described in the Introduction.
The purpose of present study was to clarify whether antibiotic crown (E. coli amino acids) cells formed crown cells nema following the addition of amino acids. Several unique objects were observed before the addition of amino acids (Figs 5 and 6). After the addition of amino acids, objects that had not been observed before the addition of amino acids were observed. Most of the objects observed after the addition of amino acids were round or rod-like (Figures. 8, 9, 10, 11, 12, 13, 17, and 18).
The findings showed that new objects arose after combining antibiotic crown E.coli amino acid cells and amino acids. These objects were named crown E.coli amino acid cells nema.
As described previously, crown cells nema consist of regenerated DNA crown cells (13).
Objects consisting of numerous round cells were observed at 3 days after addition of amino acids (Figures. 15 and 16). These objects were not observed before the addition of amino acids and showed crown cells nema proliferation.
Thus, the present findings demonstrated that antibiotic crown E. coli amino acids cells produced crown cells nema after stimulation with amino acids as a partner.
These cells were formed from the DNA crown cells that were prepared with Sph, DNA (E. coli), adenosine, and monolaurin. These findings also demonstrated that antibiotic crown cells precede the formation of crown cells nema. Thus, the origin of crown cells nema are DNA crown cells and antibiotic crown cells, which have the ability to behave as proto-cells for crown cell generation, in addition to having anti-Bacillus characteristics.
A previous report showed that most crown Asci glu-glu cells nema had a complex structure. Consequently, grouping of crown cells nema may be difficult based on their size and shape (13). Also, in the case of crown E.coli glu-glu cells nema, most are typically simple, round, or rod-like in shape (14). Previous experimental results suggested that such phenomena may arise due to differences in the source of DNA (derived from single E. coli cells and multiple ascidian cells) (14). The present findings showed that most crown E. coli amino acid cells nema have a simple round shape. The formation of objects using amino acids as a partner may be similar to the shape of crown cells nema, which were formed using antibiotic crown E. coli glu-glu cells,
On the other hand, these objects may differ slightly in shape compared to objects that were formed using antibiotic crown E. coli glu-glu cells and antibiotic crown E.coli amino acids cells. Specifically, when using Glu-Glu as a partner, objects are typically rod-shaped, whereas when using amino acids, they are typically round. In all cases, crown cells nema formed using antibiotic crown E. coli cells are simple in shape.
To clarify whether DNA (E. coli) crown cells formed simple crown cells nema, and whether DNA (Ascidian) formed complex cells nema, further studies on the formation of crown cells nema using various DNA crown cells are necessary.
The present findings may give further implications for the appearance of microorganisms. There are approximately 415–615 ´ 1028 microorganisms on earth; however, of these, more 99.9% remain unidentified (14). In a previous study (14), based on the observation that crown cells nema were living, it was proposed that the appearance of unidentified microorganisms may be associated with the proliferation of crown cells nema and that such crown cells nema or crown cells were an unidentified microorganism. Also, in present experiment, it was demonstrated that crown cells nema were living (Figures. 19 and 20). Therefore, the present findings may support these hypotheses.
It was proposed that DNA crown cells could be employed in the medical field for antibiotic production. In addition, DNA crown cells may be used to clarify the mechanisms on the appearance of unidentified microorganisms present in environments such as soil, animal guts, and hot springs.
This study also identified antibiotic crown E. coli amino acid cells. The objects derived from antibiotic crown E. coli-amino acid cells after stimulation with a partner (amino acids) are named crown E. coli amino acid cells nema.
- Inooka S., Preparation and cultivation of artificial cells. App. Cell Biol.25.15-18.2012 ISSN 1881-0772
- Inooka S., Preparation of Artificial Cells Using Eggs with Sphingosine-DNA. J, Chem. Eng. Process Technol. 17, 277, 2016. doi.10.4172/2157-77048.1000277
- Inooka S., Aggregation of sphingosine-DNA and cell construction using components from egg white. Integrative Molecular Medicine. 3 (6). 1-5, 2016. doi 10.157761/imm.1000256
- Inooka S. Isolation of Antibiotic Producing Cells from Plate Culture of Egg Powder Enclosing DNA (Bovine Meat) Crown Cells and Beef Extract. Annals of Reviews and Research 12(5) ARR.MS.ID. 555850(2025)
- Inooka S. Separation of Antibiotic-Producing Cells from Beer Produced in Co-cultures of DNA (Streptomyces) Crown Cells with Yeast Annals of Reviews and Research 12(3) ARR.MS.ID. 555839(2025)
- Inooka S., Separation of antibiotic producing cells from culture fluids of egg white powder enclosed DNA (Streptomyces) crown cells and yeast. International Journal of Bioprocess & Biotechnological Advancements 10 (1) 499-504, 2025 ISSN: 2380-0259
- Inooka S., Separation of Antibiotic-Producing Cells from Agar Cultures of Egg Powder-Enclosed DNA (hepato-blastoma cell Line: HepG2) Crown Cell and Yeast. American Journal of Biomedical Science & Research 2025 26(2) DOI;10.34297/AJBSR 2025..26.003417. ISSN;2642-1747
- Inooka S., Isolation of Antibiotic-Producing Cells from Cultures of Egg Cultures of Egg Powder Enclosing DNA (Hepg2) Crown Cells and Salmon Roe. Trends in General Medicine 2025, 3(1):1-5, ISSN:2996-3893
- Inooka S., Antibiotic-Producing Cells Produced from A Plate Culture of Egg Powder Enclosing DNA (Nannochloropsis Species) Crown Cells and Yeast. Scientific Journal Biology & Life Sciences Vol.2, 2 (2025) ISSN 2694-166X, DOI;10.3552/SJBLS.2025.03.000582
- Inooka S., Antibiotic-Producing Cells in Milk Cultures of Egg Powder-Enclosed DNA (Ascidians Sea Squirt) Crown Cells Cultured with Peptide (Glu-Glu) Partners. International Journal of Bioprocess & Biotechnological Advancements 10(1),505-511, 2025 ISSN:2380-0259
- Inooka S., Biochemical and Systematic Preparation of Artificial cells. The global Journal of Research in Engineering Vol. 17. NOBC. 2017
- Inooka S., Systematic Preparation of Artificial Cells (DNA Crown Cells). J. Chem. Procces Technol.,8,2017. Doi.104172/2157-2048.100027
- Inooka S., Microscopic and cultivation of objects (Crown Asc.-glu-glu cells nema) from agar cultures of antibiotic crown Asc-glu-glu cells stimulated with (Glu-Glu) as a partner. Archives in Biomedical Engineering & Biotechnology 8 (3), 2026. ISSN 2687-8180 Doi;10.18552//ABEB.2026.000689
- Inooka S., Microscopic Appearance of Objects (Crown E.coli-glu-glu cells nema) from Agar Cultures of Antibiotic Crown E.coli-glu-glu Cells Stimulated with Glu-Glu. Chem Pharm Res., 2026, 8(1), 1-7 ISSN 2689-1050